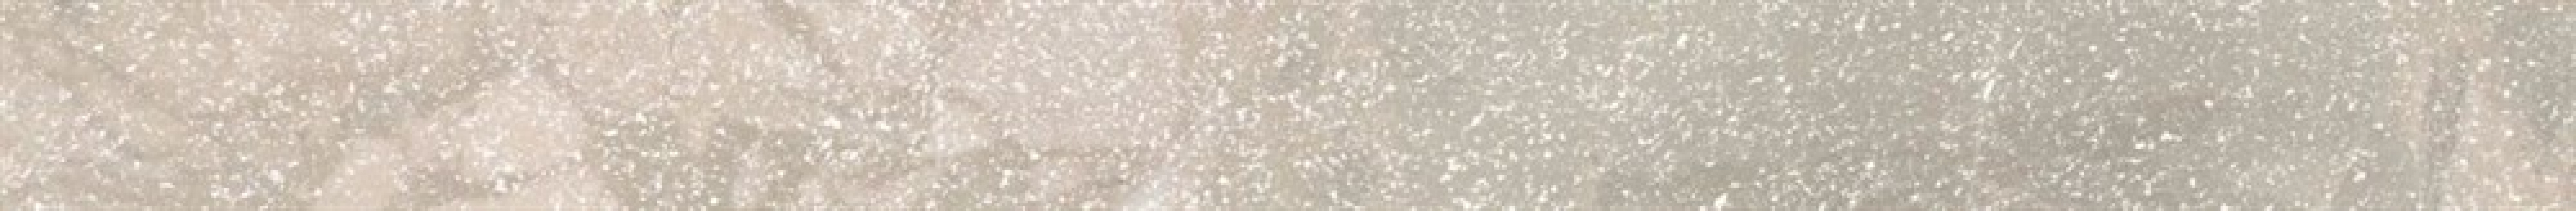
Плитка 30x3 19мм KMB2SPA003BR Бордюр Рабат Стоун бежевый матовый обрезной матовая Kerama Marazzi Плитка 30x3 19мм KMB2SPA003BR Бордюр Рабат Стоун бежевый матовый обрезной матовая Kerama Marazzi

Плитка 30x3 19мм KMB2SPA003BR Бордюр Рабат Стоун бежевый матовый обрезной матовая Kerama Marazzi
Артикул: 242384
- Производитель: Kerama Marazzi
- Страна: Россия
- Коллекция: Рабат
- Размеры, см: 30x2.5, площадь 0.0075м2
Цена: 327 руб/шт
| Толщина, мм | 19 |
| Цветовой тон | бежевый |
| Поверхность | матовая |
| Назначение | стена и пол |
Другие товары из этой коллекции
Плитка 30x12 13мм KML2FMF004BR Плинтус Рабат серый матовый обрезной матовая Kerama Marazzi
Артикул: 242393
Цена: 373 руб/шт
Подробнее(открыть в новом окне)
Плитка 30x12 13мм KML2FMF003BR Плинтус Рабат бежевый матовый обрезной матовая Kerama Marazzi
Артикул: 242392
Цена: 373 руб/шт
Подробнее(открыть в новом окне)
Плитка 30x12 13мм KML2FMF002BR Плинтус Рабат Стоун серый матовый обрезной матовая Kerama Marazzi
Артикул: 242391
Цена: 373 руб/шт
Подробнее(открыть в новом окне)
Плитка 30x12 13мм KML2FMF001BR Плинтус Рабат Стоун бежевый матовый обрезной матовая Kerama Marazzi
Артикул: 242390
Цена: 373 руб/шт
Подробнее(открыть в новом окне)
Мозаика 30x30 9мм KMD2MSA002BR Декор Рабат мозаичный серый матовый обрезной матовая Kerama Marazzi
Артикул: 242389
Цена: 632 руб/шт
Подробнее(открыть в новом окне)
Мозаика 30x30 9мм KMD2MSA001BR Декор Рабат мозаичный бежевый матовый обрезной матовая Kerama Marazzi
Артикул: 242388
Цена: 632 руб/шт
Подробнее(открыть в новом окне)
Плитка 30x3 19мм KMB2SPA006BR Бордюр Рабат серый матовый обрезной матовая Kerama Marazzi
Артикул: 242387
Цена: 327 руб/шт
Подробнее(открыть в новом окне)
Плитка 30x3 19мм KMB2SPA005BR Бордюр Рабат бежевый матовый обрезной матовая Kerama Marazzi
Артикул: 242386
Цена: 327 руб/шт
Подробнее(открыть в новом окне)
Плитка 30x3 19мм KMB2SPA004BR Бордюр Рабат Стоун серый матовый обрезной матовая Kerama Marazzi
Артикул: 242385
Цена: 327 руб/шт
Подробнее(открыть в новом окне)
Плитка 30x12 13мм KMB2BDA004BR Бордюр Рабат серый матовый обрезной матовая Kerama Marazzi
Артикул: 242383
Цена: 410 руб/шт
Подробнее(открыть в новом окне)
Плитка 30x12 13мм KMB2BDA003BR Бордюр Рабат бежевый матовый обрезной матовая Kerama Marazzi
Артикул: 242382
Цена: 410 руб/шт
Подробнее(открыть в новом окне)
Плитка 30x12 13мм KMB2BDA002BR Бордюр Рабат Стоун серый матовый обрезной матовая Kerama Marazzi
Артикул: 242381
Цена: 410 руб/шт
Подробнее(открыть в новом окне)
Плитка 30x12 13мм KMB2BDA001BR Бордюр Рабат Стоун бежевый матовый обрезной матовая Kerama Marazzi
Артикул: 242380
Цена: 410 руб/шт
Подробнее(открыть в новом окне)
Плитка 30x3 9мм KM3060B0061R Рабат 2 серый матовый структура обрезной матовая Kerama Marazzi
Артикул: 242379
Цена: 1725 руб/м2
Подробнее(открыть в новом окне)
Плитка 60x30 9мм KM3060B0051R Рабат 2 бежевый матовый структура обрезной матовая Kerama Marazzi
Артикул: 242378
Цена: 1725 руб/м2
Подробнее(открыть в новом окне)
Плитка 60x30 9мм KM3060B0041R Рабат серый матовый обрезной матовая Kerama Marazzi
Артикул: 242377
Цена: 1679 руб/м2
Подробнее(открыть в новом окне)
Плитка 60x30 9мм KM3060B0031R Рабат бежевый матовый обрезной матовая Kerama Marazzi
Артикул: 242376
Цена: 1679 руб/м2
Подробнее(открыть в новом окне)
Плитка 60x30 9мм KM3060B0021R Рабат Стоун серый матовый обрезной матовая Kerama Marazzi
Артикул: 242375
Цена: 1679 руб/м2
Подробнее(открыть в новом окне)
Плитка 60x30 9мм KM3060B0011R Рабат Стоун бежевый матовый обрезной матовая Kerama Marazzi
Артикул: 242374
Цена: 1679 руб/м2
Подробнее(открыть в новом окне)